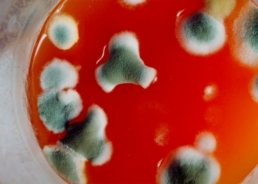

More conspiracy than not
“More conspiracy than not” was a dinner I organised for the Coromandel Press issue ‘EAT’. Four ladies and four gentlemen were invited and the whole was conceived as a painting, a composition of characters, personalities and egos. I did not invite myself as I did not want to determine the form the evening could take; I reserved myself the honour of serving instead. A chef whom I have known for some time by the name of Gilles prepared the food. All the guests had a tie microphone and everything they said was recorded for the duration of the dinner. When the dinner was over the table was abandoned with all the food and the drinks left on it. I then photographed and filmed the deterioration of the food over a period of three weeks, after which the neighbours began to complain about the smell. The resulting film has the voices over the rotting food but the guests themselves are absent. This piece was originally conceived as an installation where the voices would be played back over the rotting food, as a kind of Vanitas.
Year2001LocationParisMediumVideo